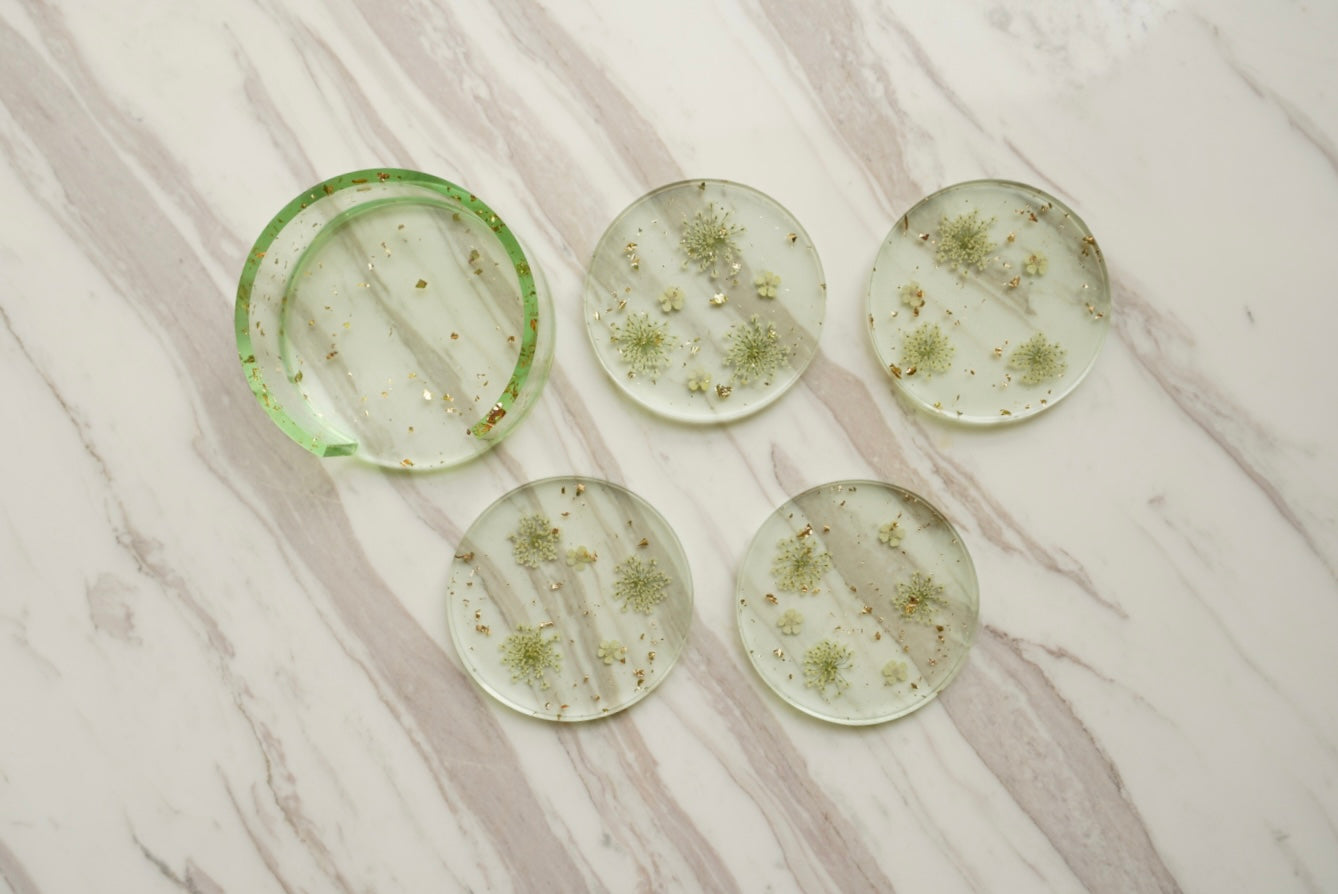
'VERDANT WALTZ' Coaster Set (Set of 4)

Softly Spoken
'VERDANT WALTZ' Coaster Set (Set of 4)
'VERDANT WALTZ' Coaster Set (Set of 4)
Couldn't load pickup availability
Intricate coaster set made with epoxy resin and real spirea flowers. The Verdant Waltz coaster set captures the beauty of living greenery, sealed in resin, offering a modern botanical statement for your home.
100% handmade — each coaster is carefully crafted with hand-pressed real flowers and handpoured epoxy resin
Dimensions: approx. 9 cm × 9 cm (fits standard mugs & glasses)
Unique variations — real flowers have slight color/variety variations due to seasonal availability, and please note that air bubbles may occur inside the coaster
Easy to clean — please avoid harsh chemicals
Gift-ready — comes wrapped in eco-friendly packaging, ideal for birthdays, housewarmings, or “just because” surprises
These coasters bring the outdoors inside and make a lovely accent in living rooms, dining areas, desks, or garden-themed tea settings. To preserve their shine, avoid placing very hot pots directly on them and clean gently with a damp cloth.
Share